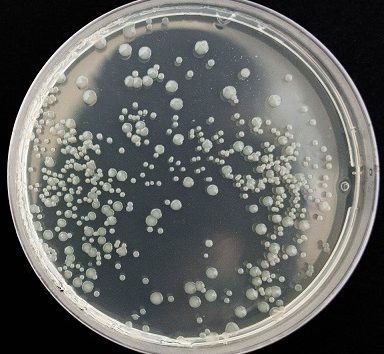

ATARs for every podiatry course in Australia 2017
As at September 2017, there are 8 accredited undergraduate podiatry courses in Australia and 3 postgraduate courses. For entry into a podiatry course commencing in…
Read More ATARs for every podiatry course in Australia 2017>